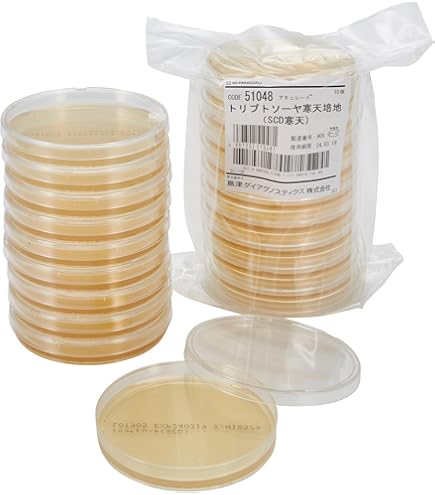

新入荷
再入荷
人気メーカー・ブランド 50004,51007_羊血液寒天/ タイムセール
 タイムセール
タイムセール
終了まで
00
00
00
999円以上お買上げで送料無料(※)
999円以上お買上げで代引き手数料無料
999円以上お買上げで代引き手数料無料
通販と店舗では販売価格や税表示が異なる場合がございます。また店頭ではすでに品切れの場合もございます。予めご了承ください。
商品詳細情報
| 管理番号 |
新品 :8509631745
中古 :8509631745-1 |
メーカー | cdca98a3d7 | 発売日 | 2025-04-06 03:12 | 定価 | 2200円 | ||
|---|---|---|---|---|---|---|---|---|---|
| カテゴリ | |||||||||

![20330K01 未使用 DXアンテナ 直列ユニット中間用1端子形[2K・4K・8K対応] WU7CS 20個入 Y5](https://auctions.c.yimg.jp/images.auctions.yahoo.co.jp/image/dr000/auc0504/users/04bae777dc601336edabe5e07093a7369d8ae06e/i-img1000x1000-1711949306upliar96793.jpg)





